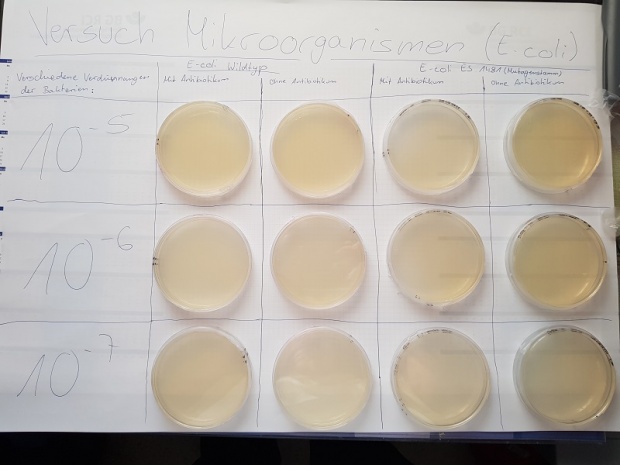
natlab1.jpg
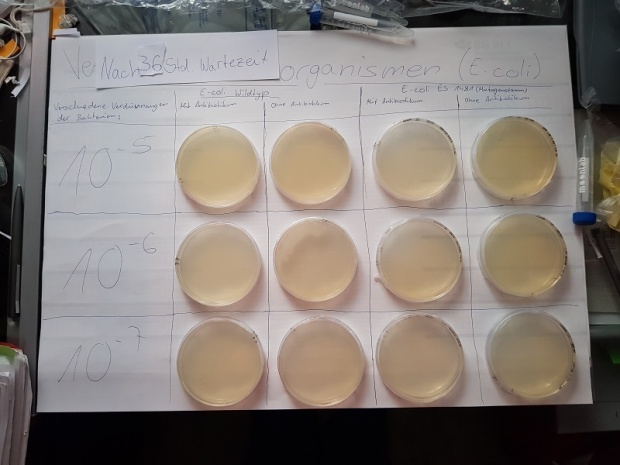
natlab2.jpg
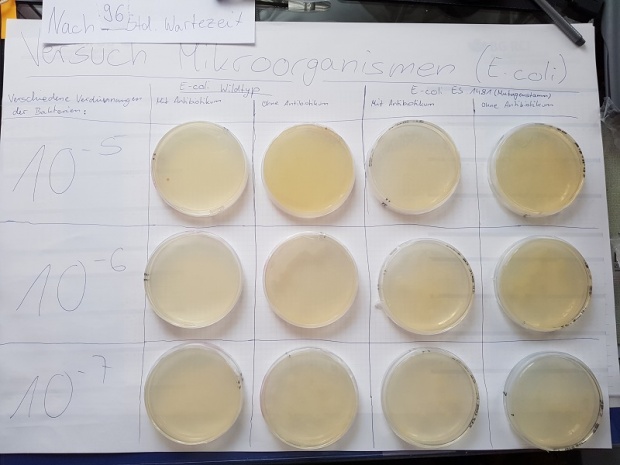
natlab3.jpg
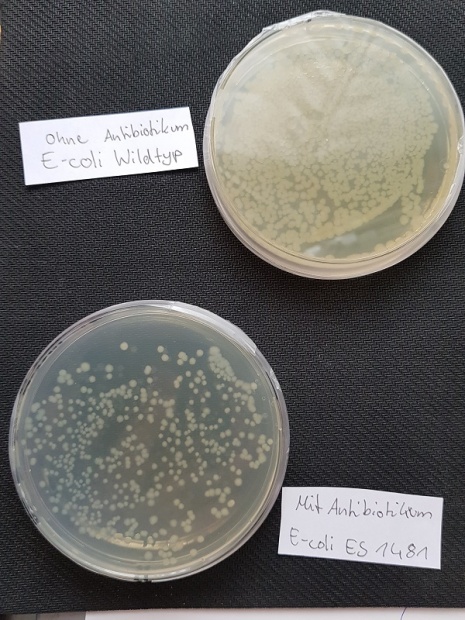
natlab4.jpg

Am 04.07.2017 waren wir, die Klasse 10.3 in Begleitung von Frau Sommer und Herrn Richter, im NatLab der Freien Universität zu Berlin.
Im NatLab Berlin haben wir uns mit dem Thema Evolution beschäftigt und dazu Versuche durchgeführt. Bei diesen Versuchen wurden wir von Lehramtsstudenten angeleitet, damit wir die Versuche auch wissenschaftlich korrekt durchführen.
Wir wurden in insgesamt 4 Gruppen mit jeweils 4 bis 6 Leuten eingeteilt. Hierbei hat jeder der 4 Gruppe einen eignen Versuch durchgeführt.
Zur Auswahl der Versuche standen die Themen:
1. Stammbäume: Wer sind die nächsten Verwandet der Vögel? Hierbei hat diese Gruppe sich Skelette von verschiedenen Tieren angeschaut und eine Rangliste aufgestellt inwieweit die Tiere mit einander verwandt sind.
2. Angepasstheit: Wanzen erobern das Wasser. Die Gruppe hat sich mit der Anpassung von Landwanzen beschäftigt und wie sie im Wasser überlegen können. Hierbei hat sich diese Gruppe auf die Rückenschwimmer und Ruderwanzen spezialisiert.
3. Die Variabilität einer Zuckererbse. Hierbei hat sich die Frage ergeben, wie es denn sein kann, dass Pflanzen, die unter gleichen Bedingungen gezüchtet wurden, trotzdem anders sind (einige Pflanzen haben zwei Triebe anstatt nur einen).
4. Wie entwickeln sich Medikamentenresistenzen? Diese Gruppe hat sich die E-coli Bakterien genauer angeguckt, um herauszufinden, wie sich Medikamentenresistenzen bilden. Dabei haben sie zwei Arten von E-coli Bakterien (Wildtyp und eine Mutation) betrachtet.

Nachdem dann die Gruppen eingeteilt waren, konnte es auch schon losgehen mit den Versuchen. Doch bevor wir wirklich anfingen, gab es noch eine wichtige Sache zu besprechen, die Sicherheit, damit auch keiner zu Schaden kommt.
Nachdem auch dies erledigt wurde, ging es dann auch los mit dem experimentieren. Als dann jede Gruppe so nach ca. 3 Stunden fertig war mit dem Experimentieren, ging es dann zum „Museumsrundgang“, wobei jede Gruppe ihren Versuch erklärte und versuchte, es so gut wie möglich zu veranschaulichen, was leider nicht immer so gut geklappt hat.
Alles in allem kann man sagen, dass der Tag sehr viel Spaß gemacht hat und sehr informativ war.
Julia Dambeck (10.3)


